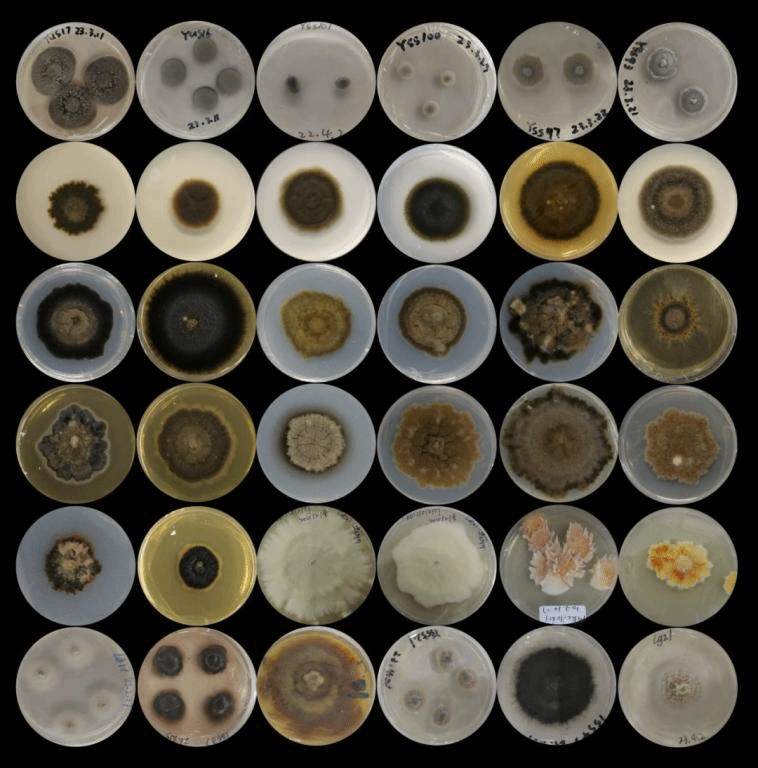

贵州省人民政府于2023年6月20日发布《关于2022年度贵州省科学技术奖励的决定》,其中由贵州大学牵头申报,贵州理工学院为第二完成单位,我院卢永仲博士作为主要完成人的项目“小型子囊真菌的系统分类及其物种资源多样性”获自然科学奖二等奖。本次获奖是卢永仲博士继2021年获得贵州省自然科学奖二等奖后再次获得该项殊荣。
近年来,学院以卢永仲博士为代表的科研团队针对小型子囊真菌分类理论不完善,重要类群系统分类混乱,科、属、种间分类界限不清等科学问题,开展了小型子囊真菌系统分类和物种多样性研究。团队完善了小型子囊真菌多个类群的分类理论体系,修正了传统形态学分类的缺陷,利用多基因遗传信息和现代生物信息学技术,创立了小型子囊真菌重要类群更贴近自然的分类体系,并基于相关分类理论创新,创立了一系列新分类阶元,包括1个新目、2个新科、18个新属、106个新物种。该团队还从部分活性菌株中分离纯化并鉴定了多个具有抗癌活性的新结构天然产物,为生物制药等大健康产业提供了丰富的微生物菌种和药物先导化合物资源。本次获奖项目的5篇代表作均刊载真菌学领域排名Top1的SCI顶刊、中科院一区的《Fungal Diversity》(IF 20.372),并有3篇被评为高被引论文。

团队获得的部分优异菌种资源

团队获得的部分小型子囊菌有性型形态特征

团队获得的部分小型子囊菌无性型形态特征